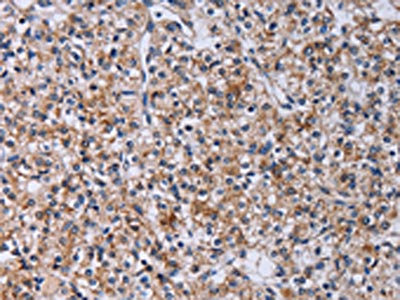

-
中文名稱:CA4兔多克隆抗體
-
貨號:CSB-PA109564
-
規格:¥1100
-
圖片:
-
The image on the left is immunohistochemistry of paraffin-embedded Human colon cancer tissue using CSB-PA109564(CA4 Antibody) at dilution 1/30, on the right is treated with fusion protein. (Original magnification: ×200)
-
The image on the left is immunohistochemistry of paraffin-embedded Human prostate cancer tissue using CSB-PA109564(CA4 Antibody) at dilution 1/30, on the right is treated with fusion protein. (Original magnification: ×200)
-
Gel: 8%SDS-PAGE, Lysate: 40 μg, Lane: Human normal lung tissue, Primary antibody: CSB-PA109564(CA4 Antibody) at dilution 1/300, Secondary antibody: Goat anti rabbit IgG at 1/8000 dilution, Exposure time: 40 seconds
-
-
其他:
產品詳情
-
Uniprot No.:
-
基因名:CA4
-
別名:CA IV antibody; CA4 antibody; CAH4_HUMAN antibody; CAIV antibody; Car4 antibody; Carbonate dehydratase IV antibody; Carbonic anhydrase 4 antibody; Carbonic dehydratase antibody; Carbonic dehydratase IV antibody; EC 4.2.1.1 antibody; Retinitis pigmentosa 17 (autosomal dominant) antibody; RP17 antibody
-
宿主:Rabbit
-
反應種屬:Human
-
免疫原:Fusion protein of Human CA4
-
免疫原種屬:Homo sapiens (Human)
-
標記方式:Non-conjugated
-
抗體亞型:IgG
-
純化方式:Antigen affinity purification
-
濃度:It differs from different batches. Please contact us to confirm it.
-
保存緩沖液:-20°C, pH7.4 PBS, 0.05% NaN3, 40% Glycerol
-
產品提供形式:Liquid
-
應用范圍:ELISA,WB,IHC
-
推薦稀釋比:
Application Recommended Dilution ELISA 1:2000-1:5000 WB 1:500-1:2000 IHC 1:25-1:100 -
Protocols:
-
儲存條件:Upon receipt, store at -20°C or -80°C. Avoid repeated freeze.
-
貨期:Basically, we can dispatch the products out in 1-3 working days after receiving your orders. Delivery time maybe differs from different purchasing way or location, please kindly consult your local distributors for specific delivery time.
-
用途:For Research Use Only. Not for use in diagnostic or therapeutic procedures.
相關產品
靶點詳情
-
功能:Reversible hydration of carbon dioxide. May stimulate the sodium/bicarbonate transporter activity of SLC4A4 that acts in pH homeostasis. It is essential for acid overload removal from the retina and retina epithelium, and acid release in the choriocapillaris in the choroid.
-
基因功能參考文獻:
- CA4 is a novel tumour suppressor in Colorectal cancer through the inhibition of the Wnt signalling pathway by targeting the WTAP-WT1-TBL1 axis. CA4 methylation may serve as an independent biomarker for the recurrence of Colorectal cancer . PMID: 26071132
- Carbonic anhydrase 4 is lost in papillary thyroid carcinoma but not thyroid nodules PMID: 24880201
- Although CA IV has been shown to be active in mediating CO2 and HCO3 (-) transport in many important tissues like kidney and lung, and in isolated cells from brain and muscle, the gene for CA IV appears not to be essential. PMID: 24146379
- Coexpression of CAIV with MCT1 and MCT4 resulted in a significant increase in MCT transport activity. PMID: 24338019
- membrane-associated CA IV contributes robust catalytic activity intracellularly, and this activity participates in regulating H(+) dynamics in the cytosol PMID: 23297198
- Two SNPs of carbonic anhydrase IV, which are responsible for amino acid changes, were found. The frequencies of these SNPs were not significantly different between the caries-free group and the group with caries PMID: 22021688
- compared the subcellular localization and post-translational processing of wild-type (WT)- and retinitis pigmentosa 17 mutant-CAIV in three cell types PMID: 20626030
- The results suggest that the expression level of carbonic anhydrase IV may be important to maintain retina function in retinitis pigmentosa. PMID: 20450258
- renal injury inflicted by expression of human carbonic anhydrase IV folding mutants was markedly enhanced by haploinsufficiency of the endoplasmic reticulum cochaperone p58(IPK). PMID: 20308551
- binding by extracellular loop 4 of the human AE1 Cl-/HCO3- exchanger PMID: 11994299
- carbonic anhydrase IV binds EC4 of NBC1, and this interaction is essential for full NBC1 activity PMID: 14567693
- mutation was found to cosegregate with the retinitis pigmentosa RP17 phenotype in two large families PMID: 15090652
- CA inhibitors may have long-term adverse effects on vision. PMID: 15563508
- characterized the CA IV expressed in Capan-1 cells PMID: 17409381
- A novel mutation has been identified in CA4 that provides further evidence that impaired pH regulation may underlie photoreceptor degeneration in retinitis pigmentosa PMID: 17652713
- CAIV p.R14W sequence variant found in one of the patients with Bothnia dystrophy phenotype is benign polymorphism in population of northern Sweden. PMID: 18344446
- Apoptosis induced by the CA IV mutants could be prevented, at least partially, by treating the cells with dorzolamide, a CA inhibitor PMID: 19211803
顯示更多
收起更多
-
相關疾病:Retinitis pigmentosa 17 (RP17)
-
亞細胞定位:Cell membrane; Lipid-anchor, GPI-anchor.
-
蛋白家族:Alpha-carbonic anhydrase family
-
組織特異性:Expressed in the endothelium of the choriocapillaris in eyes (at protein level). Not expressed in the retinal epithelium at detectable levels.
-
數據庫鏈接:
Most popular with customers
-
-
YWHAB Recombinant Monoclonal Antibody
Applications: ELISA, WB, IHC, IF, FC
Species Reactivity: Human, Mouse, Rat
-
Phospho-YAP1 (S127) Recombinant Monoclonal Antibody
Applications: ELISA, WB, IHC
Species Reactivity: Human
-
-
-
-
-